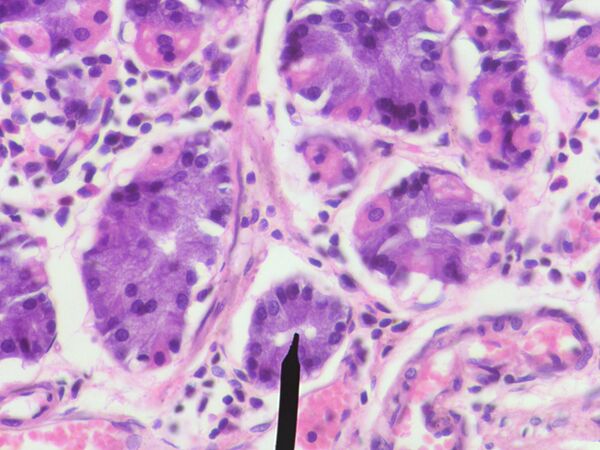

Пепсин
| Пепсин | |
|---|---|
 Пепсин в комплексе с пепстатином | |
| Другие названия: | Пепсин А |
| Генетические данные | |
| Код гена: | 8885 (HGNCid) |
| Структура и функция белка | |
| Тип белка: | протеаза |
| Функции: | пищеварение |
| Другое | |
| Молекулярные взаимодействия: | пепстатин |
| Database Links | |
| Шифр КФ: | 3.4.23.1 |
Пепси́н (др.-греч. πέψις — пищеварение) — протеолитический фермент класса гидролаз (КФ 3.4.23.1) образуется из своего предшественника пепсиногена, вырабатываемого главными клетками слизистой оболочки желудка, и осуществляет расщепление белков пищи до пептидов. Присутствует в желудочном соке человека, млекопитающих, птиц, пресмыкающихся и большинства рыб.
Открыт Теодором Шванном в 1836 году. Джон Нортроп в 1930 году получил его в кристаллическом виде.
Общие сведения
Пепсин — глобулярный белок с молекулярной массой около 34500. Молекула пепсина — полипептидная цепь, которая состоит из 340 аминокислот, содержит 3 дисульфидные связи (—S—S—) и фосфорную кислоту. Пепсин — эндопептидаза, то есть фермент, который расщепляет центральные пептидные связи в молекулах белков и пептидов (кроме кератинов и других склеропротеинов) с образованием более простых пептидов и свободных аминокислот. С наибольшей скоростью пепсин гидролизует пептидные связи, образованные ароматическими аминокислотами — тирозином и фенилаланином, однако, в отличие от других протеолитических ферментов — трипсина и химотрипсина, — строгой специфичностью не обладает.
Пепсин используют в лабораториях для изучения первичной структуры белков, в сыроварении и при лечении некоторых заболеваний желудочно-кишечного тракта.
Естественным ингибитором пепсина является пепстатин.
Изопепсины
Всего известно до 12 изоформ пепсина (Коротько Г. Ф., 2006), которые различаются молекулярным весом, электрофоретической подвижностью, оптимумами рН протеолитической активности, при разном рН с неодинаковой скоростью гидролизуют разные белки, условиями инактивации.
Собственно пепсином называется пепсин, имеющий шифр КФ 3.4.23.1.
По У. Г. Тейлору (Коротько Г. Ф., 2007), в желудочном соке человека 7 изопепсинов, 5 из них с чётко различающимися свойствами:
- Пепсин 1 (собственно пепсин) — максимум активности при рН = 1,9. При рН = 6 быстро инактивируется.
- Пепсин 2 — максимум активности при рН = 2,1.
- Пепсин 3 — максимум активности при рН = 2,4 — 2,8.
- Пепсин 5 («гастриксин») — максимум активности при рН = 2,8 — 3,4.
- Пепсин 7 — максимум активности при рН = 3,3 — 3,9.
Существует иная терминология: «пепсин-А» (собственно пепсин); «пепсин-B» (шифр КФ 3.4.23.2) имеет синонимы: «желатиназа» (gelatinase), «парапепсин I» (parapepsin I); «пепсин-C» (шифр КФ 3.4.23.3), синонимы: «гастриксин» (gastricsin), «парапепсин II» (parapepsin II).
Роль пепсина в пищеварении
Пепсины играют значительную роль в пищеварении у млекопитающих, в том числе у человека, являясь ферментом, выполняющим один из важных этапов в цепочке превращений белков пищи в аминокислоты. Железами желудка пепсин вырабатывается в неактивном виде, переходит в активную форму при воздействии на него соляной кислоты. Пепсин действует только в кислой среде желудка и при попадании в щелочную среду двенадцатиперстной кишки становится неактивным.
У мужчин дебит пепсина составляет от 20—35 мг в час (базальная секреция) до 60—80 мг в час (секреция, стимулированная пентагастрином, максимальная). У женщин — на 25—30 % меньше. Главные клетки слизистой оболочки желудка секретируют, резервируют и выводят неактивную форму пепсина — профермент пепсиноген. Превращение пепсиногена в пепсин происходит в результате отщепления с N-концевого участка пепсиногена нескольких пептидов, один из которых играет роль ингибитора. Процесс активации идёт в несколько стадий и катализируется соляной кислотой желудочного сока и самим пепсином (автокатализ). Пепсин обеспечивает дезагрегацию белков, предшествующую их гидролизу и облегчающую его. Как катализатор он обладает протеазным и пептидазным действием.
Протеолитическая активность пепсина наблюдается при рН < 6, достигая максимума при pH = 1,5—2,0. При этом один грамм пепсина за два часа может расщеплять ~50 кг яичного Альбумина, створаживать ~100 000 л молока, растворять ~2000 л желатина.
Лекарственные препараты на основе пепсина
Для медицинских целей в качестве лекарственного средства вырабатывают из слизистой оболочки желудка свиней. Выпускается в виде порошка (лат. pepsinum) или в виде таблеток в смеси с ацидином (лат. асіdin-рерsini), в составе комбинированных препаратов (Панзинорм-Форте и другие). АТС-код пепсина A09AA03. АТС-код комбинации пепсина с кислотосодержащими препаратами A09AC01.
При недостатке пепсина в организме (болезнь Менетрие и другие) назначается заместительная терапия пепсиносодержащими препаратами.
Выпускается в смеси с сахарной пудрой. Белый или слегка желтоватый порошок сладкого вкуса со слабым своеобразным запахом.
Применение и дозы препарата. Внутрь по 0,2—0,5 г (детям от 0,05 до 0,3 г) 2—3 раза в день перед едой или во время еды, в порошках или в 1—3 % растворе разведённой соляной кислоты.
Действие лекарства. Пепсин расщепляет белки до полипептидов, после воздействия пепсина начинается процесс переваривания белков в пищеварительном тракте.
Показания к применению. Ахилия, гипо- и анацидные гастриты, диспепсия.
Противопоказания, возможные побочные явления. Не установлены.
Хранение. В хорошо закупоренных банках, в прохладном (от + 2 до +15 °C), защищённом от света месте.
Таблетки, содержащие 1 часть пепсина и 4 части ацидина (бетаина гидрохлорида). При введении в желудок ацидин гидролизуется и отделяет свободную соляную кислоту.
Показания к применению. Расстройства пищеварения при ахилии, гипо- и анацидных гастритах, диспепсии.
Форма выпуска. Таблетки по 0,5 и 0,25 г.
Применение и дозы препарата. Для взрослых: 1 таблетка по 0,5 г 3 — 4 раза в день. Для детей — от 1/4 таблетки (массой 0,25 г) до 1/2 таблетки (массой 0,5 г) в зависимости от возраста, 3 — 4 раза в день. Таблетки перед приёмом растворяют в 1/4 — 1/2 стакана воды. Принимают во время или после еды.
Другие торговые наименования. Асіdolрерsin, Асіpepsol, Веtacid, Рерsacid, Рерsamin.
Сыроделие
Пепсин или в чистом виде, или в составе сычужной закваски применяется для сворачивания молока при приготовления сыров. Сычужный фермент состоит из двух основных компонентов — химозина и пепсина.
Под свёртыванием молока понимаются процессы коагуляции основного его белка — казеина и образования молочного геля. Строение казеина таково, что за ферментативное свёртывание «ответственна» только одна пептидная связь в белковой молекуле. Разрыв белковой молекулы по этой ключевой связи и приводит к свёртыванию молока.
Химозин является тем ферментом, который по своей природе обеспечивает разрыв данной связи, при этом мало затрагивая другие. Пепсин затрагивает более широкий спектр пептидных связей в казеине. Химозин, не являясь сильным протеолитом (разрывает незначительное число пептидных связей казеина), выполняет подготовительную работу для деятельности протеаз молочнокислой микрофлоры. Под действием химозина и пепсина расщепление полипептидных цепей казеина идёт по пептидной связи между 105—106 аминокислотами (фенилаланин-метионин) с отщеплением в сыворотку участка со 106 по 169 аминокислоту — гидрофильного гликомакропептида, при этом максимальное количество белка остаётся в сгустке.
Для приготовления многих элитных видов сыров применяют сычужный фермент, содержащий 90-95 % химозина и 5-10 % пепсина. Но, для некоторых других сыров (сулугуни, брынза) допускается использование пепсина в чистом виде. «Народные» рецепты приготовления сыров обычно рекомендуют использование для ферментации пепсиносодержащие лекарственные препараты («Ацидин-пепсин» и подобные).
Мукорпепсин (англ. mucorpepsin) — протеолитический фермент класса гидролаз. Шифр КФ 3.4.23.23. Мукорпепсин получается из грибов Mucor pusilus и Мucor miehei. Применяется в пищевой промышленности в качестве заменителя сычужных ферментов животного происхождения.
На российском рынке встречается, как «Пепсин, микробиальный ренин, фермент для приготовления мягких и рассольных сыров» «растительного происхождения», японского производства, в котором в качестве молокосвёртывающего фермента используется мукорпепсин.
Литература
- Коротько Г. Ф. Желудочное пищеварение. Краснодар, 2007, — 256 с ISBN 5-93730-003-3.
- Коротько Г. Ф. Желудочное пищеварение в технологическом ракурсе. — Кубанский научный медицинский вестник. 2006, № 7-8 (88-89), с. 17-22.
- Пепсин // Словарь медицинских препаратов. — 2005.